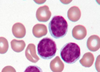

Lymphocytosis and Lymphoid Leukemias Flashcards
(58 cards)
Similar to the myeloid counterparts (i.e. neutrophils, eosinophils), lymphocytes can be expanded in the blood in either reactive or neoplastic processes and this is referred to as:
lymphocytosis
A lymphocytosis is defined as an absolute lymphocyte count of
>4k/uL.
Clinical scenario, morphology, duration, and WBC count are important in differentiating benign (reactive) from neoplastic lymphocytoses.
In general, reactive increases in lymphocytes are_________, while neoplastic
proliferations are_______
transient
chronic (persisting for >6months)
Reactive expansions in general do not exceed
_______, while neoplastic lymphocytoses can cause extremely elevated WBC counts.
10k/uL
________expansions tend to have heterogeneous-appearing lymphocytes, which vary in size and cytoplasm
________proliferations tend to be composed of monotonous-appearing lymphocytes.
reactive
neoplastic
Most common causes of reactive leukocytosis are:
Infectious
transient stress lymphocytoses
List common infectious causes of lymphocytosis
Mononucleuosis (from EBV), cytomegalovirus (CMV), hepatitis, varicella,
adenovirus, toxoplasmosis, and pertussis
What are common causes of transient stress lymphocytoses?
trauma, myocardial infarctions, or seizures and rapidly reverse within
hours
Describe the morphology of lymphocytes seen in mononucleosis
heterogeneous, large, and have abundant, lightly basophilic cytoplasm, which
encroaches on neighboring red blood cells

In mononucleosis, lymphocytes represent ______, which are
responding to the EBV-infected B cells.
cytotoxic T cells
A presumptive diagnosis of infectiousmononucleosis can be made from peripheral blood smear examination by meeting the following 3 criteria:
1) >50% mononuclear cells in the differential (monocytes and lymphocytes)
2) marked lymphocytic heterogeneity
3) >10% reactive lymphocytes (>10/100 leukocytes).
(Confirmation of the diagnosis is made with identification of
heterophil antibodies in the “monospot” test.)
Neoplastic proliferations of mature lymphocytes include:
chronic lymphocytic leukemia (CLL), hairy cell leukemia, splenic marginal zone lymphoma, large granular lymphocytic leukemia, adult T-cell leukemia (ATLL), and Sezary syndrome
In neoplastic lymphocytosis, do we expect to see all disorders to present with elevated lymphocyte counts?
No, but abnormal lymphocyte morphology is certainly observed in the majority of these diseases.
In unexplained lymphocytosis, morphology may not be enough to identify the disease thus we should perform:
Flow cytometry
________will identify what
predominant cell type is present, as_______ does not allow definite distinction
between T cells, B cells, or NK cells.
Flow cytometry
morphology
By definition, the neoplastic proliferations will show
evidence of clonality how?
by monoclonal light chain expression
or immunophenotypic aberrancy
(abnormal antigen expression, such as CD5 on B cells).
(kappa or lambda-restricted populations of B cells)
would be polyclonal and demonstrate an admixture of kappa- and lambda-expressing B cells and CD4(+) and CD8(+) T cells.
Reactive expansions
Be able to recognize a histogram and what it is telling you
note the X and Y axsis. These will tell you if you have just kappa, just lambda or mixed

When neoplastic lymphoid cells involve the blood predominately, the process is termed a
leukemia
When neoplastic lymphocytes are predominately tissue-based (lymph nodes, spleen, liver), the process is termed
lymphoma.
How does WHO classify lymphoid neoplasms?
By cell of origin, cell size/morphology, genetics, and clinical features
Acute Lymphoblastic Leukemia/Lymphoma
(ALL) is predominately a ______ neoplasm defined by increased lymphoblasts
ALL is as immature lymphoid neoplasm***
pediatric
What is the precursor cell in ALL?
Precursor B cell in the bone marrow